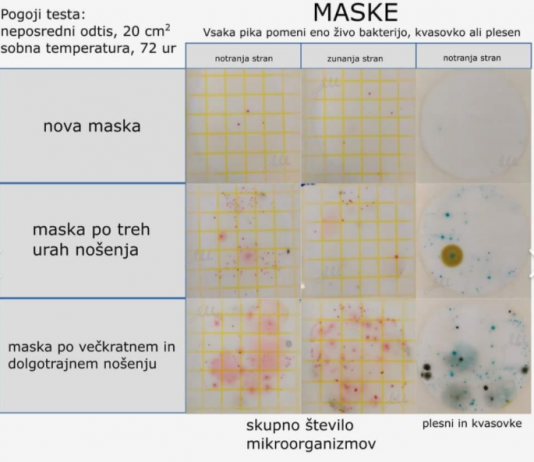
Je tudi do vas prišla Facebook objava o škodljivosti mask? Mikrobiologinja opozarja, da z maskami ščitimo druge, sebi pa praviloma ne škodujemo

Bojana Beović o izstopu Fafangela iz vladne skupine za covid-19: Nihče ni bil pri svojem delu omejen
Predstojnik Centra za nalezljive bolezni Nacionalnega inštituta za javno zdravje (NIJZ) Mario Fafangel zapušča svetovalno skupino za covid-19 pri ministrstvu za zdravje, so za...
Petkova epidemiološka statistika je zelo črna. Ugasnilo je 34 življenj oseb, ki so bile pozitivne na koronavirus, kažejo uradni podatki.
Trend obolelosti s koronavirusom v...
Celje 7. oktober 2020 - Minister za infrastrukturo Jernej Vrtovec je danes preko Facebook profila napovedal, da se bo z naslednjim letom uveljavil predpis,...
Ljubljana 14. oktober 2020 - Včeraj so v Sloveniji potrdili rekordnih 707 okužb z novim koronavirusom. Opravili so 4902 testa. Bolnišnično oskrbo je potrebovalo...
Ministrstvo za infrastrukturo je obvestilo vse avtobusne prevoznike, ki imajo koncesijo za izvajanje javnega potniškega medkrajevnega linijskega prometa, da se zaradi odločitve Vlade Republike...
“Ni referenc, ki bi rekle, ker je to tako in toliko zraslo, je škodljivo za vdihavanje. Ker tudi ni res. Cel smisel mask je...
Z Odlokom o začasni prepovedi ponujanja in prodajanja blaga in storitev neposredno potrošnikom na področju voznikov in vozil v Republiki Sloveniji, Vlada za omejitev...
Ministrstvo za izobraževaje, znanost in šport je objavilo posodobljen seznam odprtih vrtcev, ki zagotavljajo nujno varstvo za otroke, katerih starši so zaposleni, in varstva...
V ponedeljek, 9. 11. 2020, predvidoma med 9. in 10. uro, bo zaradi nadgradnje spletne aplikacije UJP e-plačila moten dostop.
Uprava Republike Slovenije za javna...
Zastrupljevalci mladih umov, ki ne psihološko ne kognitivno niso sposobni, da bi se obranili pred tovrstnim pranjem možganov, v Sloveniji že nekaj časa prodirajo...
























![[Video] Britanska papiga, ki zna zapeti melodije pevke Beyonce, je tako slavna, da ima svoj Instagram profil](https://celjskiglasnik.si/wp-content/uploads/2020/09/Papiga-1-218x150.png)
![[VIDEO] V Berlinu zasačili lisičko, ki je namesto kokoši kradla čevlje; v brlogu so jih našli vsaj 100](https://celjskiglasnik.si/wp-content/uploads/2020/07/fox-218x150.jpg)